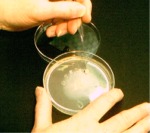
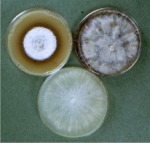

Species that are related possess similar traits and by knowing the name of a fungus species, its characteristics and how it will act in particular situations (their biology and ecology) can be predicted. Some species cause disease, others break down wood (decay) or debris in the soil. Still others develop an association with root tips of plants (about 95% of tree species depend on these mycorrhizal associations). Certain genera of fungi are known to produce allergic reactions in humans; others produce toxins. |
|||||||||||
| Identifications normally require microscopic examination of the fungus fruiting structures. However, in instances where these structures are not evident, sampling and isolating the fungus into culture (into Petri dishes on nutrient media) become necessary. Dr. Burdsall is experienced in both of these procedures that lead to fungal identifications. | |||||||||||
|
|
|||||||||||
| Sampling and culturing fungi can be accomplished from any substrate: | |||||||||||
|
|
air | ||||||||||
|
|
in-home surfaces | ||||||||||
|
|
interior wall cavities | ||||||||||
|
|
wood in service (building or structure) | ||||||||||
|
|
diseased or decaying trees | ||||||||||
| (using increment core or from other sources) | |||||||||||
|
|
mushrooms, conks and crust-fungi | ||||||||||
|
|
wood chips and soil | ||||||||||
| The type of decay that a fungus causes can be determined by culturing the fungus from decaying trees and wood in buildings and structures. This is important because some types of decay cause more severe strength loss than others in a short amount of time. In the case of air quality samples, the fungi that are in the air as live spores (and otherwise unseen) can be identified from culture. | |||||||||||
|
|||||||||||
 |
| Microscopic examination is necessary to identify fungi whether a fruiting body or a culture. |
 |
| Fruiting structures of Bjerkandera fumosa causing decay of elm |
 |
| Sampling decayed wood to be cultured for fungus identification |
|
| Culturing from decayed wood sample |
| Copyright © 2004-2012 Fungal & Decay Diagnostics, LLC |